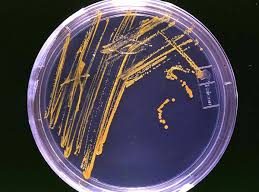
Reasons Behind Culture Media Agar Failing to Solidify and Effective Solutions
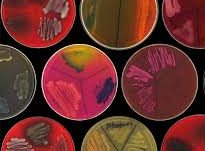
Understanding Microbial Strain Degradation and How to Prevent It

Difference Between Nutrient Agar (NA) and Plate Count Agar (PCA)
News 26 11 月, 2024
Introduction For those familiar with microbiological testing, colony count testing varies across industries, including food, air, water, and food contact surfaces. While some standards require Plate Count Agar (PCA), others call for Nutrient Agar (NA). So, what’s the difference between these two culture media? Formulations and Key Differences …
Listeria monocytogenes: The Hidden Threat in Low-Moisture Foods
News 26 11 月, 2024
Introduction As awareness of food safety increases, the food industry is actively seeking methods to control foodborne pathogens. A recent review published in Trends in Food Science & Technology highlights the survival characteristics of Listeria monocytogenes in low-moisture foods and how this impacts the effectiveness of thermal processing in food…
Tips for Mastering the Pour Plate Technique
News 26 11 月, 2024
Introduction The pour plate technique is a crucial step in biological experiments, widely used in bacterial culture, molecular biology, environmental monitoring, water quality analysis, and microbiological testing. Accurate and efficient plate pouring is the foundation for experimental success. Beginners often encounter challenges, so here are some prac…
Causes and Solutions for Elevated Blank Test Values
News 26 11 月, 2024
Introduction Blank test values play a crucial role in quality control during sample analysis. These values reflect the combined impact of noise from testing instruments, impurities in reagents, contamination during handling, and environmental factors on sample measurements. Understanding the causes of elevated blank test values is essential for ensuring…
Viable Norovirus Persistence in Aquatic Microenvironments: Insights and Findings
News 26 11 月, 2024
Introduction Human norovirus is the leading cause of acute gastroenteritis worldwide. Despite its significant public health impact, human norovirus remains challenging to cultivate in laboratory conditions. Consequently, environmental fate studies of norovirus rely on molecular methods or culturable surrogate viruses. However, these methods often overes…
Baird-Parker Agar: Key Applications and Fundamental Principles in Bacteriological Research
News 25 11 月, 2024
Introduction Baird-Parker Agar is a specialized medium that plays a vital role in bacteriological research. Its selective capabilities make it highly effective for detecting and isolating pathogenic Staphylococcus aureus. Widely used in food safety and clinical microbiology, this medium is an indispensable tool for ensuring public health. This article e…
Understanding the Concepts and Differences Between Microbial Group, Genus, Species, and Strain
News 25 11 月, 2024
Introduction Microbial classification uses several important terms like genus, species, and strain to describe and organize microorganisms. Understanding these distinctions is crucial for microbiologists and researchers working with bacteria and other microbes. This article delves into the concepts of microbial group, genus, species, and strain, explain…
Reasons Behind Culture Media Agar Failing to Solidify and Effective Solutions
News 13 11 月, 2024
Agar, also known as agar-agar or jelly powder, is a crucial component in culture media used for microbial growth. Derived from certain types of red algae, agar is available in powder or strip form and consists primarily of large polysaccharides. When used as a solidifying agent in microbiological media, agar’s performance is influenced by its inherent qual…
Understanding Microbial Strain Degradation and How to Prevent It
News 13 11 月, 2024
Microbial strains are critical for various applications, from food safety to pharmaceuticals. However, over time, strains can experience genetic mutations, leading to what is known as microbial strain degradation. This process impacts the viability and productivity of microorganisms and can affect research and production outcomes. Here’s a look at the caus…
The Manufacturing Process and Equipment Requirements for Powdered Culture Media
News 9 10 月, 2024
Powdered culture media are essential components in microbiology laboratories for cultivating microorganisms. The production process involves various methods, including ball milling mixing, spray drying, vacuum freeze-drying, and vacuum drying. Each method has its own advantages, and the choice of technique depends on the specific requirements of the cultur…
Introduction to Infusion Powders Used in Culture Media
News 9 10 月, 2024
Introduction Infusion powders are essential raw materials in microbiological culture media, widely used to promote the rapid growth and development of microorganisms. These powders are derived from plant or animal tissues through a series of processes, including soaking, heating, pH adjustment, filtration, and spray drying. Infusion powders are rich in …
Understanding Initial Contamination Bacteria: Detection and Importance
News 9 10 月, 2024
Initial contamination bacteria, or initial bioburden, refers to the microorganisms present on a product before sterilization. These bacteria originate from various contamination sources, including raw materials, manufacturing processes, environments, and packaging methods. The detection of initial contamination is crucial in determining the sterilization p…